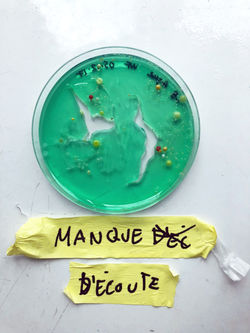
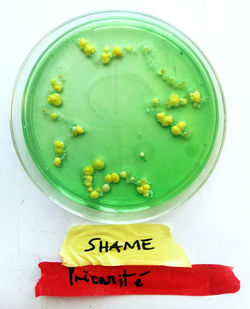

Alix Roederer
![]() | ![]() | ![]() | ![]() | ![]() | ![]() |
|---|---|---|---|---|---|
![]() | ![]() | ![]() | ![]() | ![]() | ![]() |
![]() | ![]() | ![]() | ![]() | ![]() | ![]() |
![]() | ![]() | ![]() | ![]() | ![]() | ![]() |
![]() | ![]() | ![]() | ![]() | ![]() | ![]() |
![]() | ![]() | ![]() | ![]() | ![]() | ![]() |
![]() | ![]() |
Bacterial Conversations
2018
Performance
This participative performance piece aims to disrupt the feeling of dissociation and lack of responsibility towards others that define modern society. This project creates deep and meaningful conversations between strangers through the very intimate medium of their bacteria.
These bacterial conversations revolve around the subject of trauma. I believe individual and societal identities are constructed around, within or in avoidance of past traumas. The piece consists of an event where bacteria are collected from zones of trauma on the body of the audience and used to inoculate Petri dishes. The participant decides what part of the body to swab – e.g., eyes for mental illness, ears for verbal aggression, etc. People who are survivors of similar traumas are invited to have a bacterial discussion in the same Petri dish. It is also possible for the audience to make conversations happen between different experiences, for example between systemic racism and sexual assault. The participants decide what Petri dish they choose to inoculate with their bacteria.
The bacteria are then left to perform. Beautiful cosmic patterns are created around these hard subjects.